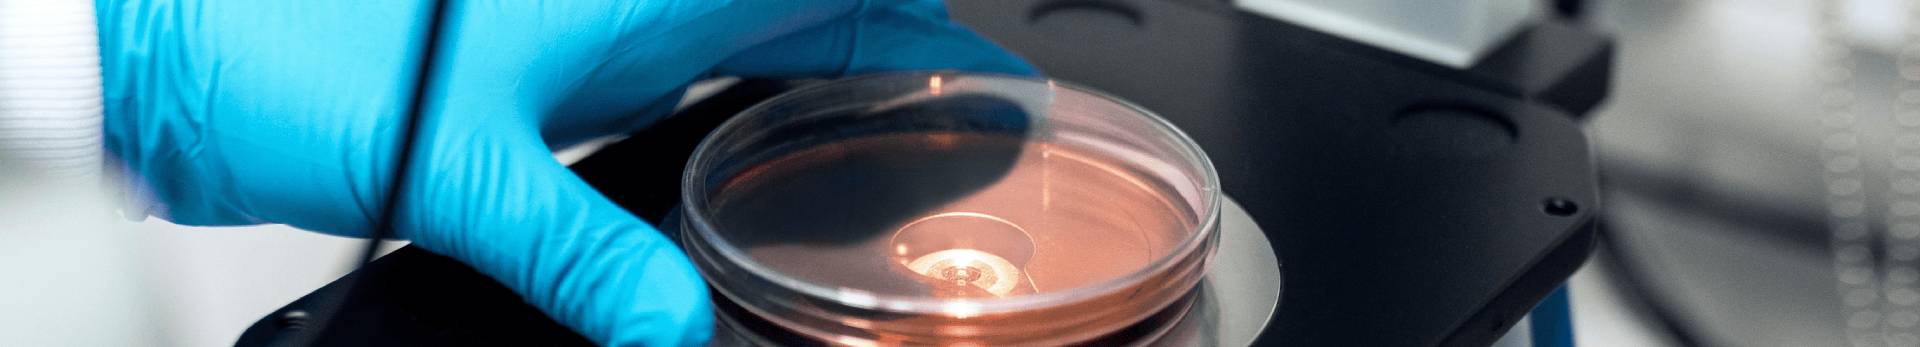
Znanstveno vijeće slika

Znanstveno vijeće Veterinarskog instituta je tijelo sastavljeno od stručnjaka iz različitih područja veterinarske znanosti. Njegova uloga uključuje vođenje istraživačkih projekata, ocjenjivanje znanstvenih radova i sudjelovanje u donošenju odluka o istraživačkim prioritetima instituta.